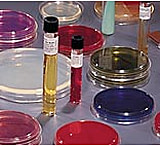
Image of BD BBL Prepared Media Stacker PlatesA7 Agar to Pseudosel Agar, BD Diagnostics 221780 Group A Selective Strep Agar, With 5% Sheep Blood (ssA)

Search Results for “midit uniforme plate dishes” — 2,101 products / 4,886 models — Page 1
No results were found for your search query "midit uniforme plate dishes". The following are results for a similar search "media uniforms plates dies"
reset
Sort by
Best Match
Show
60
reset
Show
60
Search Feedback
Did you find what you were looking for? Tell us what you think of our search results and how we can improve.Compare (0)
1 item has been added
Add at least two items to compare